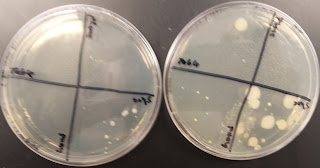

Room Temperature on the left and 37 degree Celsius on the right.
Room Temperature Incubation Colonies:
- Bottom of Shoe- 100
- Palm of Hand- 2
- Lab Table- 5
- Phone Screen- 0
Room Temperature Incubation Organisms:
- Bottom of Shoe- 10
- Palm of Hand- 1
- Lab Table- 4
- Phone Screen- 0
37 degrees Celsius Incubation Colonies:
- Bottom of Shoe- 50
- Palm of Hand- 100
- Lab Table- 40
- Phone Screen- 40
37 degrees Celsius Incubation Organisms:
- Bottom of Shoe- 5
- Palm of Hand- 5
- Lab Table- 4
- Phone Screen- 2
Comparison:
When comparing both petri dishes the colonies and organisms
varied immensely. You can definitely tell which organisms could
only thrive in room temp compared to the 37 degree Celsius. Also
the organisms that are the same in both dishes only vary in size,
concluding that they enjoy that climate much better.
Outcomes:
Based on the outcomes of the experiment I am a little surprised
of how the petri dishes developed in the different conditions. When
looking at the room temperature dish it was interesting to see that my
phone screen had no growth of any type of bacteria and fungus when
compared to my hand. On the other hand in the 37 degree Celsius dish
there was a profound amount of growth in every section of the dish. As
for the shoe sample in both dishes, I wasn't surprised about the results
because in reality I am testing multiple places that I have walked to and from.
Discrepancies:
None to report.
Room Temp Petri Dish Close up
37 degree Celsius Petri Dish Close up
|

Greetings,
ReplyDeleteThe results of my experiment is very similar to yours. I tested microbes on phone, microscope, notebook and inside of a shoe. Surprisingly, there was not much bacterial growth on phone, microscope and notebook although they are commonly used objects in labs. Nonetheless, inside of shoe had a significant growth; corresponding to your results.
Furthermore, I like to point out to the temperature differences. Many experiments of our classmates suggest that bacterial growth is encouraged in warm temperatures than room temperature. This is good in the sense that places that have room temperatures will have less bacterial growth.